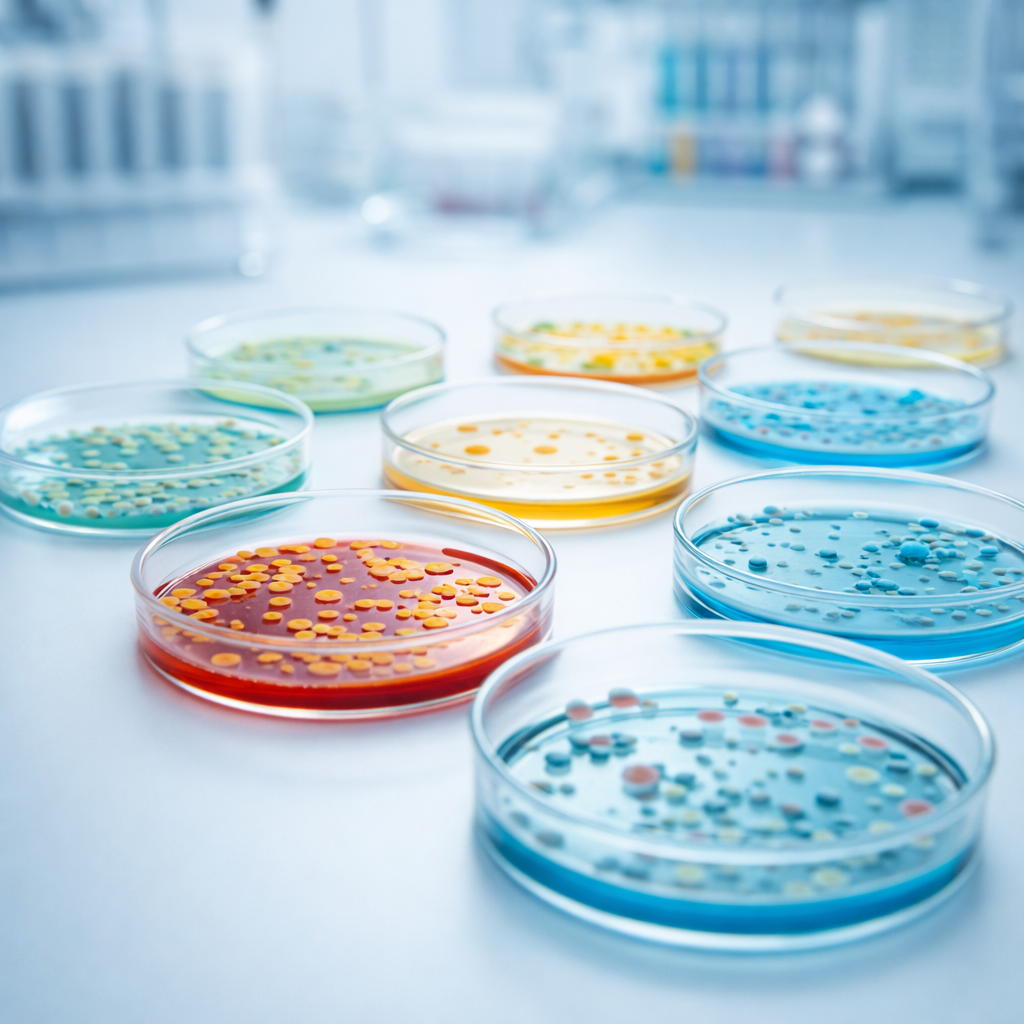
Analisi Microbiologia & Tamponi

OMOCISTEINA, RISCHIO CARDIOVASCOLARE ED ALTRE PATOLOGIE
a cura di dott.ssa Sara Giacaroni L’omocisteina è un aminoacido solforato che si forma nel nostro organismo a partire dalla metionina, aminoacido essenziale, che viene introdotto con l’alimentazione attraverso il consumo di carne, uova, latte e legumi. (1)Fondamentalmente, l’omocisteina è un prodotto di scarto che di norma viene trasformato in una sostanza innocua utile all’organismo…
Leggi tutto